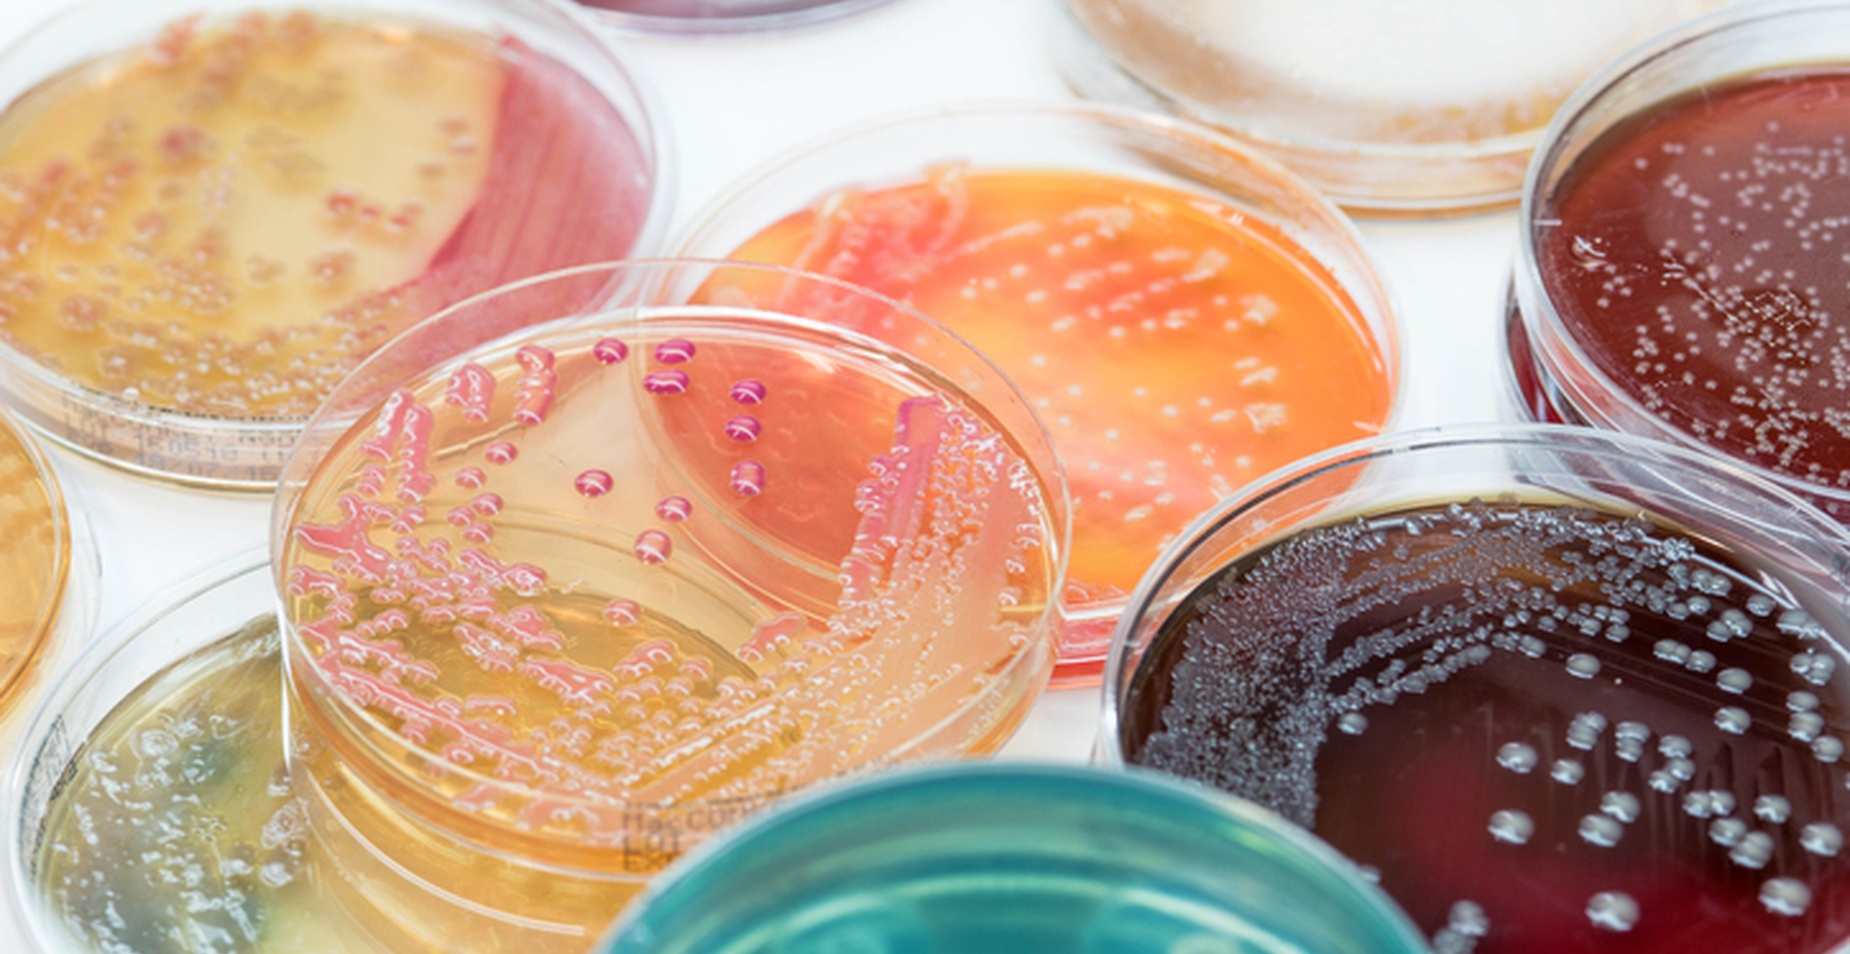
smart_crop_1850x954

Scientific Excellence, Personal Partnership
What truly distinguishes Perritt Laboratories is our expert-driven, high-touch approach. Unlike high-volume laboratories that rely on automated workflows or distributed teams, every study at Perritt is overseen by experienced scientists committed to data integrity and clear communication. We believe trust is built through consistency, transparency, and a genuine partnership with our clients.
Our Commitment to You
We hold our laboratory to the highest operational standards to ensure your evaluations are handled with the care and precision they deserve. Our work is guided by a steadfast commitment to these core principles:
- Scientific rigor: Accurate, defensible data produced by seasoned experts
- Regulatory alignment: Deep understanding of U.S. and international standards
- Personal attention: Direct communication with the scientists performing your work
- Reliability: A 50-year reputation built on precision, quality, and trust
Resources
Recent Posts